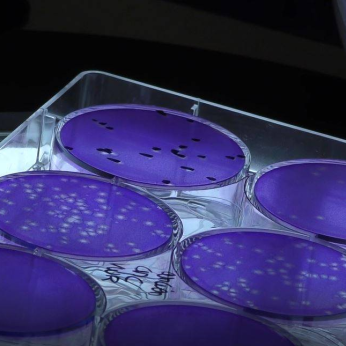

ABL, Inc. - Advanced BioScience Laboratories
Exhibitor
Information
ABL, Inc. is a CDMO and CRO providing GMP manufacturing and immunology solutions for gene therapies, oncolytics, vaccines and other immunotherapeutics. We specialize in immuno-oncology, infectious diseases, neurological diseases and chronic diseases. ABL has a global footprint, with facilities in the U.S. and Europe, offering integrated process development platforms for GMP virus and protein manufacture, bioanalytical services, biomarker identification and immunological testing.
Please visit us at www.ablinc.com and email us at info@ablinc.com to discuss how we can help advance your innovative therapies and vaccines with a revolutionary partnership!
Profile
BiotechContract ManufacturingContract Research